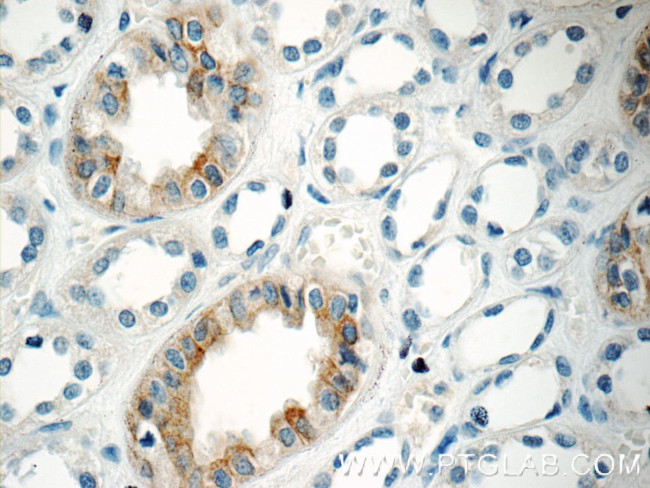
GPR3 Antibody in Immunohistochemistry (Paraffin) (IHC (P))

Search
Proteintech
GPR3 Polyclonal Antibody
{{$productOrderCtrl.translations['antibody.pdp.commerceCard.promotion.promotions']}}
{{$productOrderCtrl.translations['antibody.pdp.commerceCard.promotion.viewpromo']}}
{{$productOrderCtrl.translations['antibody.pdp.commerceCard.promotion.promocode']}}: {{promo.promoCode}} {{promo.promoTitle}} {{promo.promoDescription}}. {{$productOrderCtrl.translations['antibody.pdp.commerceCard.promotion.learnmore']}}
产品信息
20847-1-AP
种属反应
已发表种属
宿主/亚型
分类
类型
抗原
偶联物
形式
浓度
规格
纯化类型
保存液
内含物
保存条件
运输条件
产品详细信息
Immunogen sequence: DAHSPPLYT YLTLLPATYN SMINPIIYAF RNQDVQKVLW AVCCCCSSSK IPFRSRSPSD V (271-330 aa encoded by BC032702)
靶标信息
The G-protein-coupled receptor (GPCR) superfamily is comprised of an estimated 600-1, 000 members and is the largest known class of molecular targets with proven therapeutic value. GPR3 is an orphan receptor with constitutive G signaling activity. GPR3 modulates a number of brain functions, including behavioral responses to stress, neurite outgrowth and amyloid-beta peptide generation suggesting that it may play a role in Alzheimer's disease.
仅用于科研。不用于诊断过程。未经明确授权不得转售。
生物信息学
蛋白别名: ACCA orphan receptor; adenylate cyclase constitutive activator; G-protein coupled receptor 3; GPCR21; Hacca; OTTHUMP00000043209; unnamed protein product
基因别名: ACCA; Gpcr20; Gpcr21; Gpcr3; GPR3
UniProt ID: (Human) P46089, (Mouse) P35413
Entrez Gene ID: (Human) 2827, (Mouse) 14748